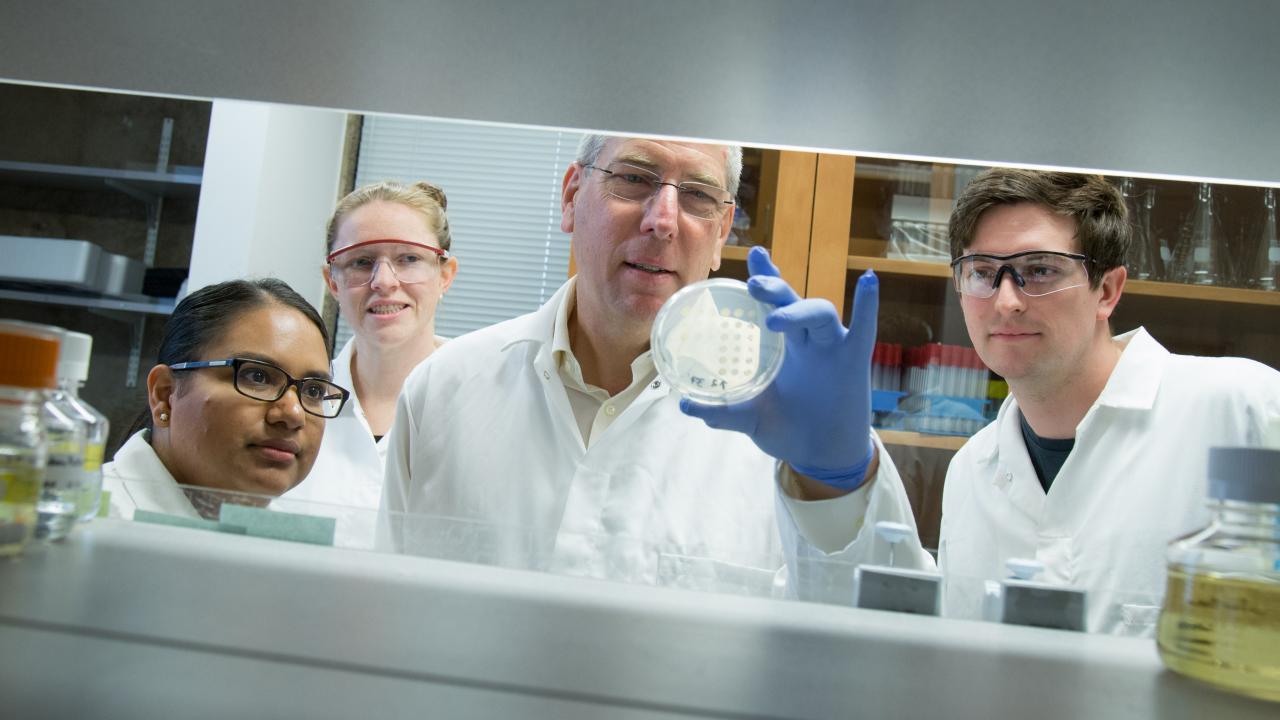

‘Curiosity Project’ Featuring CBS Dean Mark Winey Will Launch on KVIE
MORE STORIES OF CURIOSITY
The “Curiosity Project” is part of larger focus UC Davis has taken to explore the stories of curiosity across campus.
UC Davis and public television station KVIE have collaborated to create a six-segment, 30-minute show called the “Curiosity Project” that will debut at 7 p.m. Wednesday (Nov. 14).
The program explores the deeper stories behind six of our professors: What inspired them down the road of science and academia? What drives their research and their passion to help others? What do they teach us about the world?
Viewers will encounter Katia Vega, an associate professor of design, who is defining a field of “beauty technology” where tattoos can do things like gauge a person’s blood glucose level; and Professor Lee Martin, the founder of UC Davis’ Beta Lab, as he travels to schools around the area to teach young people about the joys of creating in a mobile maker lab.
The program also features Mark Winey, dean of the College of Biological Sciences, whose passion for biology was fueled by a sister who suffered from illness as a child. How did the doctors find out exactly what was wrong with her? How could this illness be prevented? These were the sparks of curiosity that led him down a road of science and discovery that continues to this day.
Also featured: Elena Siegal, an associate professor at the Betty Irene Moore School of Nursing. She transitioned to a career in health care after spending most of her work life in business and finance. They will hear what motivated her to prompt this change.
Viewers will learn about people who wouldn’t let great challenges overcome their desire to learn more about the world and help others.
For example, Geerat Vermeij, a distinguished professor of earth and planetary sciences, has lived with blindness since he was a child and today thrives as one of the world’s foremost experts in the evolution of seashells, studying the parallels of their evolution with that of human economies.
The “Curiosity Project” also includes Raquel Aldana, UC Davis associate vice chancellor for Academic Diversity and a professor of law. Like so many of our UC Davis students, she was the first in her family to receive a college degree and overcame great obstacles as an immigrant. The segment shows how her background shaped her sense of social justice and why she remains so passionate with inspiring young people to become leaders.
Media Resources
- Watch the full program online
- This story first appeared in Dateline